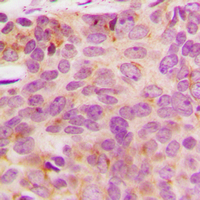

NDUFA3 Rabbit Polyclonal Antibody
CAT.NO. : ARA6633
RMB Please choose
RMB Please choose
Background
Accessory subunit of the mitochondrial membrane respiratory chain NADH dehydrogenase (Complex I), that is believed not to be involved in catalysis. Complex I functions in the transfer of electrons from NADH to the respiratory chain. The immediate electron acceptor for the enzyme is believed to be ubiquinone.
Application
|
Application |
Dilution Ratio |
|
WB |
1:500 - 1:1000 |
|
IHC |
1:100 - 1:200 |
Overview
|
Immunogen |
KLH-conjugated synthetic peptide encompassing a sequence within the center region of human NDUFA3. The exact sequence is proprietary |
|
Purification Method |
The antibody was purified by immunogen affinity chromatography |
|
Clonality |
Polyclonal |
|
Form |
Liquid in 0.42% Potassium phosphate, 0.87% Sodium chloride, pH 7.3, 30% glycerol, and 0.01% sodium azide |
|
Gene Name |
NDUFA3 |
|
Synonyms |
NADH dehydrogenase [ubiquinone] 1 alpha subcomplex subunit 3; Complex I-B9; CI-B9; NADH-ubiquinone oxidoreductase B9 subunit |
|
Gene ID (Human) |
4696 |
|
Gene ID (Mouse) |
66091 |
|
Protein ID (Human) |
O95167 |
|
Protein ID (Mouse) |
Q9C091 |
Data

Western blot analysis of NDUFA3 expression in mouse heart (A), rat heart (B) whole cell lysates. (Predicted band size: 9 kD; Observed band size: 9 kD)

Immunohistochemical analysis of NDUFA3 staining in human breast cancer formalin fixed paraffin embedded tissue section. The section was pre-treated using heat mediated antigen retrieval with sodium citrate buffer (pH 6.0). The section was then incubated with the antibody at room temperature and detected using an HRP conjugated compact polymer system. DAB was used as the chromogen. The section was then counterstained with haematoxylin and mounted with DPX.
Storage
Store at 4°C short term. For long term storage, store at -20°C, avoiding freeze/thaw cycles.
Research Use Only
For Research Use Only. Not for use in diagnostic procedures.
 New Products
New Products